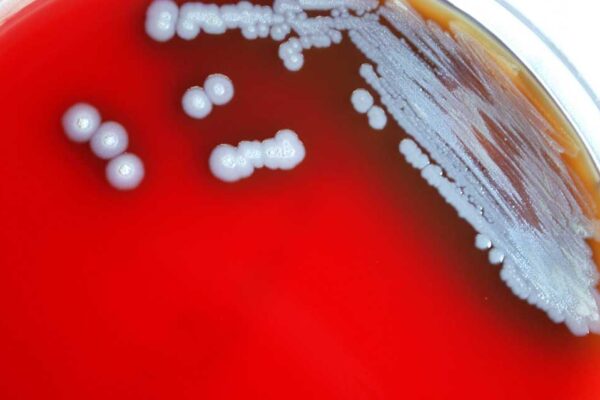

स्कूल-कॉलेज के बच्चों को कांग्रेस नेत्री रुबीना खान की नसीहत: गरबा में हिस्सा न लें, ऐसे आयोजनों से बचें
इंदौर मध्य प्रदेश में नवरात्रि के दौरान गरबा पंडालों में अन्य धर्मों के युवकों का प्रवेश रोकने के लिए कई हिंदू संगठनों ने तिलक, कलावा और आईडी कार्ड चेक करने जैसे नियम बनाए हैं, साथ ही ऐसा करने वाले युवकों को सबक सिखाने की बात भी कही है। हालांकि प्रदेश में जारी इस विवाद के…